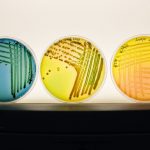

internal medicine News Archive

Provost and Vice-President (Academic)
Celebrating UM’s 2025 Emeriti
November 18, 2025 —
On November 5, the University of Manitoba hosted its annual Emeriti event at the SmartPark Innovation Hub, recognizing members of our community who have been awarded the title of Emeritus or Emerita.

Rady Faculty of Health Sciences
15 years of philanthropy and progress in GI health: Dr. Charles Bernstein’s impact as Bingham Chair
November 13, 2024 —
As the Bingham Chair in Gastroenterology for the past 15 years, Dr. Charles Bernstein's groundbreaking work in inflammatory bowel disease (IBD) research and his creation of patient-centred outpatient programs have earned international recognition, positioning Manitoba as a global leader in gastrointestinal health.

CTV Winnipeg: Dr. Ryan Zarychanski on Medical Watch
August 15, 2024 —
Dr. Ryan Zarychanski, professor of internal medicine at RFHS talks to CTV Winnipeg about the impact of a clinical trial he is co-leading to study the treatment of pneumonia in hospital settings. The project was recently awarded $6.9 million by the Canadian Institutes of Health Research.

Faculty of Agricultural and Food Sciences
Modelling for a good cause
May 29, 2024 —
Dylan MacKay typically spends his day exploring the intersection of nutrition and health. This June however, he will step out onto the catwalk to try his hand at modelling.

Rady Faculty of Health Sciences
UM researcher discovers sex-related differences of immune T-cells
May 15, 2024 —
Dr. Janilyn Arsenio’s leading-edge research is trying to understand the differences between male and female immune T-cells, a type of white blood cell that helps the immune system fight germs and protect against disease.

Rady Faculty of Health Sciences
Research aims at personalizing inflammatory bowel disease care
April 9, 2024 —
Dr. Heather Armstrong is at the forefront of inflammatory bowel disease (IBD) research and is seeking a more personalized treatment for people living with the chronic disease.

Research and International
UM researchers receive more than $1 million in new project funding
March 13, 2024 —
On Wednesday March 13, the federal government announced the Canada Foundation for Innovation (CFI) recipients of the John R. Evans Leaders Fund (JELF) for fall 2022 and spring 2023.

Research and International
Brain and Gut: working together in health and disease
March 5, 2024 —
On Wednesday March 27, 2024, join the UM Knowledge Exchange for an exploration of the connection between the brain and the gut in the context of health and Inflammatory Bowel Disease.

Research and International
Heart Health and You
February 5, 2024 —
On Wednesday February 28, 2024, leading researchers will share their insights into what you can do to protect your heart health at the UM Knowledge Exchange presentation Heart Health and You.
Research and International
Research Manitoba announces funding for three groundbreaking UM projects
August 8, 2023 —
Three new UM projects have received proof-of concept funding from Research Manitoba on July 26 totaling $346,500 over two years.






